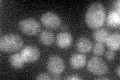
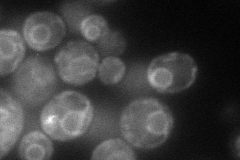
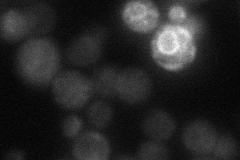

View description
Calnexin; integral membrane ER chaperone involved in folding and quality control of glycoproteins; chaperone activity is inhibited by Mpd1p, with which Cne1p interacts; 24% identical to mammalian calnexin; Ca+ binding not yet shown in yeast
Localization:
Intensity:
Fold change:
Significance:
-
C’ GFP library in SD
below threshold16.98 -
N' NOP1pr-GFP in SD
ER83.9057 -
N' TEF2pr-mCherry in SD

ER,vacuole24.6479 -
N' NATIVEpr-GFP in SD
ambiguous,ER27.2618 -
N' TEF2pr-VC and Cyto-VN in SD

#N/A0 -
C’ GFP library in SD+DTT

cytosol17.231.01No -
C’ GFP library in SD+H2O2

cytosol15.920.93No -
C’ GFP library in Starvation Media

cytosol25.231.48No -
C’ GFP library on the background of Pup2-DaMP

below threshold -
C’ GFP library on the background of CCT mutant

below threshold15.95610.939209No
